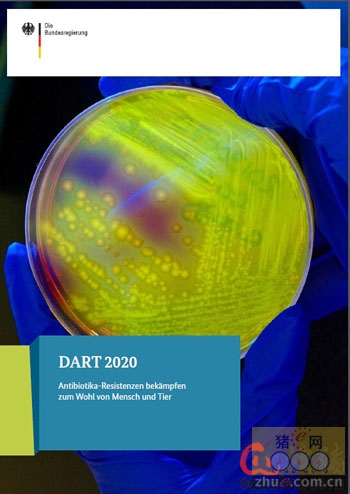

5月20日养猪业重要信息汇总
时间:2015-05-20
来源:猪易网
2015年05月20日全国外三元价格排行榜
单位:(元/公斤 )
|
区域 分类 |
|
||||||||||||||||||||||||||||||
| 东北 |
|
||||||||||||||||||||||||||||||
| 华北 |
|
||||||||||||||||||||||||||||||
|
华东 |
|
||||||||||||||||||||||||||||||
| 华中 |
|
||||||||||||||||||||||||||||||
| 华南 |
|
||||||||||||||||||||||||||||||
| 西北 |
|
||||||||||||||||||||||||||||||
| 西南 |
|
||||||||||||||||||||||||||||||
| 全国 |
|
||||||||||||||||||||||||||||||
2015年05月20日全国内三元价格排行榜
单位:(元/公斤 )
|
区域 分类 |
|
||||||||||||||||||||||||||||||
| 东北 |
|
||||||||||||||||||||||||||||||
| 华北 |
|
||||||||||||||||||||||||||||||
|
华东 |
|
||||||||||||||||||||||||||||||
| 华中 |
|
||||||||||||||||||||||||||||||
| 华南 |
|
||||||||||||||||||||||||||||||
| 西北 |
|
||||||||||||||||||||||||||||||
| 西南 |
|
||||||||||||||||||||||||||||||
| 全国 |
|
||||||||||||||||||||||||||||||
2015年05月20日全国土杂猪价格排行榜
单位:(元/公斤 )


月入两万 香港“猪肉佬”没人做

因此,DART 2020与“同一个健康”的实施是一致的。
|
区域 分类 |
|
||||||||||||||||||||||||||||||
| 东北 |
|
||||||||||||||||||||||||||||||
| 华北 |
|
||||||||||||||||||||||||||||||
|
华东 |
|
||||||||||||||||||||||||||||||
| 华中 |
|
||||||||||||||||||||||||||||||
| 华南 |
|
||||||||||||||||||||||||||||||
| 西北 |
|
||||||||||||||||||||||||||||||
| 西南 |
|
||||||||||||||||||||||||||||||
| 全国 |
|
||||||||||||||||||||||||||||||
2015年5月20日猪评:广东地区猪价高位乱象
据锐奇数据监测的当地生猪报价信息统计,2015年05月20日全国各省生猪平均价格为14.22元/千克,较昨日猪价上涨0.06元/公斤,涨幅为0.42%,最低地区为山东省,生猪平均价为13.57元/千克,两地区差异非常明显,全国大部分地区生猪行情震荡调整。

下月起生猪进东莞 须凭“电子身份证”
东莞将全面落实供莞生猪实名制,让市民吃上“放心肉”
下月起,“二师兄”进莞须凭“电子身份证”——这些信息包括:它来自哪儿,检疫证号多少,坐哪辆车过来的,同一批过来的兄弟有多少等。
“这张身份证记录了每一头生猪进入东莞的整个流程。”市农业局有关负责人说,今后如果没有这张“身份证”,或录入数据不完整、不相符等情况,一律不准进入屠场。“实名制也是让市民吃上‘放心肉’”。
记者获悉,目前东莞共认定了17批640多家供莞生猪基地,这些基地每年可提供生猪900多万头左右,保障生猪供应稳定,确保市民吃肉无忧。
供莞生猪来自哪儿也可溯源了
市农业局有关负责人说,从2006年开始,我市推行生猪产销联建制度,通过认定生猪定点供莞基地、落实生猪批发商(供应商)制度和使用供莞生猪电子标识等措施,规范我市生猪流通经营秩序,保障生猪的稳定供应和质量安全。
“电子标识在保障供莞生猪质量安全方面发挥了重要作用,近年来的瘦肉精检测合格率均在99.9%以上,但同时也伴随着标识买卖、冒用等违规行为。”上述负责人说,今年1月,我市推行供莞生猪网上交易,使每笔生猪交易有记录、有评价、可溯源,实现了电子标识无纸化升级,令供莞生猪的质量安全更有保障。“目前,我市电子标识和网上交易两种模式并行发展,生猪供应商与供莞基地可自行选择交易方式。”
据了解,截至目前,东莞共认定了17批640多家供莞生猪基地,这些基地每年可提供生猪900多万头左右,这些供莞基地分布在省内的河源、韶关、云浮、清远、江门、肇庆等地,也有广西、湖南、江西等邻近省区。
无身份证生猪不得入莞销售
供莞生猪实名制,简言之,即供莞生猪在市外基地出栏时,经检疫和药物残留检测合格后,由产地动物卫生监督机构出具检疫合格证明、戴免疫耳标,并在检疫合格证明上加贴电子标识。
市农业局表示,从2015年6月1日开始,供莞生猪电子标识全面实施信息化录入(实名制),必须录入的信息包括基地名称、检疫证号、运输车牌号码、录入日期及生猪数量等五项。届时,标识没有录入数据、录入数据不完整或不相符的视为无效标识。
为重点打击电子标识买卖谋利、采购非基地生猪等违规行为,进一步加强供莞生猪电子标识管理,推进供莞生猪网上交易,全面落实供莞生猪实名制,完善溯源体系,加强供莞生猪电子标识管理,农业部门决定:从2015年5月15日开始,没有标明有效期的供莞生猪电子标识全部废止;有标明一年有效期且尚在有效期内的标识,有效期统一截止到2015年6月30日。而且,即日起,所有新发放的电子标识有效期统一调整为3个月。
市农业局要求,各镇街食品公司要按照生猪产销联建工作有关要求,凭《基地生猪确认通知书》认定是否同意该批次生猪进入屠宰场。并且,农业、动监部门要加强对各镇街的巡查力度,规范检疫检测行为,逐一查处问题基地,同时联合公安部门重点打击生产和销售瘦肉精生猪的违法行为。
从2015年6月1日开始,供莞生猪电子标识全面实施信息化录入(实名制),必须录入的信息包括基地名称、检疫证号、运输车牌号码、录入日期及生猪数量等五项。届时,标识没有录入数据、录入数据不完整或不相符的视为无效标识。

一头猪赚150元 养猪户难言的轻松
4月中旬以来,全国猪肉价格呈上涨走势。消费者在买菜时可能要费点心思掂量掂量,但对于养殖户来说,经历了一年多时间的“寒冬”,他们更希望让肉价再“飞”一会儿。
猪肉价格持续回暖
从4月中下旬以来,猪肉价格重回上升通道。对于义乌佛堂养猪大户朱新富来说,这样的局面让他终于可以松一口气了。
事实上,朱新富对于猪价回暖的等待,足足持续了近1年半时间。2013年12月开始,生猪出栏价一路走低,以往曾被称为“猪跑跑”的“二师兄”似乎失去法力,一度成为“猪无能”———在义乌,生猪出栏价最低时甚至达到每斤4.8元的“冰点”,偶尔出现触底反弹的迹象,但多数时间也在每斤5元~6元之间徘徊。
“我从1994年开始从事规模养猪,20年了还从来没遇到过这样的行情。”这是朱新富去年4月接受记者采访时说的一句话。他介绍,按照目前的养殖成本,生猪出栏价要达到每斤7元左右才能保本,可见养殖户在过去一年中的艰辛。
猪价持续低迷带来的直接后果,是养殖户信心不足,不少人心灰意冷后退出养殖领域,导致生猪存栏量持续下滑。农业部5月15日公布的数据显示,4月份全国生猪存栏38692万头,比去年同期减少9.71%;能繁母猪存栏3971万头,同、环比分别下跌14.9%和1.7%,这是自有数据以来首破4000万头关口,也是连续第20个月持续下滑。生猪养殖业“去产能”力度和时间均远超预期。朱新富也透露,原本他的养殖场内有1100头母猪,而现在这个数字为800头,存栏量下滑明显。
然而,也正是由于存栏量的不足,导致猪肉终端市场出现供不应求的格局。业内人士认为,猪价不可能一直低迷下去,在供求关系反转的情况下,猪价重回上升通道也就不足为奇了。
预计肉价会趋于平稳,“猪周期”或将重塑
对于眼下生猪的市场行情,不少业内人士给出乐观的预计。有分析人士甚至认为,猪市如股市,2015年猪市将上演和股市一样的传奇神话———今年上半年股市的大盘指数整体上涨,不少人炒股赚到了钱。而猪市似乎也是如此:猪价整体处于猪周期“牛市”,几乎全国各地都在上涨,养猪甚至有可能出现“不赚钱都难”的局面。
而对于猪价的后市表现,义乌华统养殖有限公司总经理朱文文却认为,大涨大跌都不现实。“经历了近期较大幅度的一波涨势,猪价下一阶段预计将回归到平稳的态势中。”
值得一提的是,夏季是猪肉消费的传统淡季,这也给肉价上涨带来阻力。业内人士认为,全国各地监测的情况表明,猪价或许不会呈现持续性的直线上涨,转而步入理性通道。业内分析,猪价正在努力从节后滞涨期中走出来,但是猪市目前无有力的支撑因素,加上随着全国各地猪价普遍进入7元以后,部分养殖户会陆续出栏,这将缓解市场上供应趋紧的局面。
由于肉价此前长时间处于低谷,以往的猪周期已经被打破,未来新的猪周期或将重塑。
事实上,“猪周期”一度成为一种经济现象,其循环轨迹一般是:肉价上涨———母猪存栏量大增———生猪供应增加———肉价下跌———大量淘汰母猪———生猪供应减少———肉价上涨。而长达16个月的肉价低谷,让这一周期显得不太灵验。业内人士强调,对于养殖户来说,预防疫情、增强抗风险能力、坚持生态养殖、保证资金合理使用,依然是抵抗周期性风险的几大要素。
卖一头猪能赚150元 养殖户仍难言轻松
朱新富说,昨天义乌的生猪收购价为每斤7.6元,一头养到200斤出栏的生猪,可以赚大约150元钱。这样的数字已经让养殖户感到十分高兴。
“去年义乌至少有超过八成的养猪场亏损,现在有盈利了当然高兴。”朱新富对记者说,在猪价持续低迷的寒冬里,不少本土养殖户选择退出,而对于规模养殖场来说,退出却并不容易。他认为,未来规模化养殖、生态养殖或许是养猪户的唯一出路。
据了解,中国生猪业已经出现多次周期性波动,这个周期一般在2~3年左右。周期性大幅波动,使猪农叫苦不迭,“赚一年、赔一年”、“价高伤民、价贱伤农”,也成为生猪养殖户难以承受之重。
采访中记者了解到,眼下对于养殖场污水治理的要求仍然很高,治理成本势必分摊到养殖成本中,因此对于义乌现存的60多家养殖户来说,压力仍然不小。业内人士认为,随着“五水共治”、“三改一拆”等政策的落实,小散养猪户仍将持续退出市场。
不过有一个好消息是,今年包括玉米、豆粕在内的饲料价格并没有大幅升高,这在一定程度上缓解了养殖户的成本压力。对于后市,业内专家建议养殖户不要过度压栏,因为过度压栏会造成下半年某个时间段集中出栏,扰乱价格。另外养殖户也不要肆意大量补栏,原因在于目前市场接受和消化能力还较差,不理性的补栏行为只会增加未来的生猪供应量,让猪价再次承受压力。
生猪市场总体继续震荡上行 供给偏紧形势继续凸显
目前生猪出栏价格上涨幅度依然高于成本增加幅度,而且能繁母猪连续20个月保持下跌并且在4月份首破4000万头关口,可见猪价上涨态势依然有基本面的有力支撑。虽然5月份猪价陷入不温不火的境地,但是生猪供给偏紧形势继续凸显。当前需求清淡导致屠宰企业压价减量,预计短期以震荡调整为主。但是长期来看,能繁母猪淘汰对全国生猪供应量的影响显现将会愈加明显。如果能够安然度过5、6月份,猪价必然会有一个不错的全新局面。同时,饲料原料市场行情的弱势走低也为猪价上涨开通了道路。目前玉米价格明显滞涨,豆粕走势不及预计,这对于正处于周期性上涨前期的生猪养殖业是一大利好。建议养殖户时刻关注猪价动态,理性调整产能结构。
存栏量锐减导致涨价 养殖户不敢冒险补栏
南黄镇养殖户孙然明是养猪大户,养猪已经有15个年头了,目前家里喂养了60余头母猪。说起生猪的价格,孙然明长舒了一口气。去年他出栏了1200头肥猪,却亏损了五六万元,现在生猪价格终于回升,也算熬过“寒冬”了。
“从春节后开始,生猪出栏价一点点涨起来了。”孙然明翻开卖猪的账单和时间表给记者看:3月份时,生猪出栏价是每斤5.4元,4月初上涨到每斤6.3元,4月下旬是每斤6.7元,如今的价格持续在每斤7元左右。
“现在行情不错,我们终于稍有盈利了。”孙然明给记者算了一笔账。养猪成本主要是饲料和人工、防疫等,近几年饲料价格一直在上涨,一头猪养到120公斤左右出栏,养殖成本需要1500元左右,要卖到每斤6.5元才算保本。若是再加上设备的折旧费,利润就更少了。孙然明笑着说,如今,养殖户只能说是走出“寒冬”,要想迈入“春天”,尚有一段距离。
家里养了40余头母猪的边广勃也表示,一年多来,生猪价格持续低迷,自己就没看到过钱,现在每斤7元的生猪价格终于让他看到了希望。“去年我没有减少存栏量,一直在硬撑着,希望价格赶紧涨起来,我也算是熬到头了。”边广勃说。
存栏量锐减导致涨价
对于生猪价格持续走高的原因,业内人士分析,不少养殖户去年亏损严重,存栏量锐减,而市民对猪肉的需求量是持续的,以致生猪收购紧张,价格自然就上来了。
南黄镇畜牧兽医站工作人员介绍,去年一年,镇上的散养殖户纷纷清栏,母猪存栏量就减少了三分之二。工作人员建议,既然生猪越来越少,养殖户可以停止缩减产能,选择适当补栏恢复生产。
一名养殖户认为,接下来生猪价格应该能够快速上涨,只要涨起来,养殖户们就能很快走出亏损。
养殖户不敢冒险补栏
记者调查发现,如今虽然生猪价格上涨,但不少养殖户表示不会扩大存栏量。
“去年8月份,生猪价格一度涨到7块多,但仅仅维持了不足一个月的时间,又疯狂跌到低谷。”按照孙然明多年的养猪经验,生猪价格存在周期性规律,往往是贵一年、平一年、亏一年,但自2013年开始,生猪价格让他们这群养猪专业户完全找不到规律了。大家认为,生猪价格未来的走势并不明朗,所以不敢贸然扩大存栏量。
此外,孙然明说,即便自己有意扩大存栏量,时间上也并不允许。母猪怀孕期需要4个月,然后猪崽育肥要将近6个月,等到可以出栏也就到明年了。明年的生猪价格会如何,他更是不敢妄加猜测。
与孙然明的想法一致,边广勃也表示不会扩大存栏量。据他分析,今年的生猪价格应该会持续上升,但他不敢冒险,存栏量能维持在40头母猪左右就差不多了。
五月各地区域屠宰厂的采购压力有所放缓
最近几日猪价以小幅上涨为主,规模化养殖企业将引领行情上涨,主要是猪价到7.5元/斤左右,市场上适重猪群更受欢迎,规模化厂的量和重量在市场都更具话语权,建议养殖户根据自身猪群情况适时出栏,猪价处于赢亏平衡点上时,抓好眼前的钱袋子更显重要,要做好高温销售时猪群的应机防备。
全国生猪行情表现不一,五月猪价相比三、四月猪价大步上涨,本月猪价上升幅度明显缩窄。
南北差价继续拉大的情况下,网认为有利于下一拨猪价的稳定上涨,主要原因:北方产区的生猪交易以外调为主,只有足量的外调后,才能提升本地市场价格,而南方产量本身大大少于北方,又受禁养令的严格落实,生猪在养大大减少。
华中市场五月终端生猪交易相比三、四月更显平淡,分析认为主要是由于天气转热后,肉类消费减少,其它替代消费明显增加。南方稳定小幅上涨,北方震荡下滑的大环境下,华中猪价弱势小幅上涨,湖南与华南区相临,市场环境明显好过靠近北方的河南市场。上周东北先涨后跌,华东稳涨,华南快速上涨,华中小幅上涨。
生猪供应缺口仍然较大,雨天将加大收猪难度,天晴后气温较高,北猪南运风险加大,预计下阶段南方猪价继续上涨空间大。北方将保持弱势稳定,主要是南北差价还未回归理性位置,调运活动随着天气转热将有所减少,五月各地区域屠宰厂的采购压力有所放缓。
猪肉消费少压制猪价快速上涨,生猪供应偏紧局面虽略有所缓解,但整体市场供应仍现不足,五月猪价仍以上涨为主,但上升幅度相比三、四月收窄。
最近几日猪价以小幅上涨为主,规模化养殖企业将引领行情上涨,主要是猪价到7.5元/斤左右,市场上适重猪群更受欢迎,规模化厂的量和重量在市场都更具话语权,建议养殖户根据自身猪群情况适时出栏,猪价处于赢亏平衡点上时,抓好眼前的钱袋子更显重要,要做好高温销售时猪群的应机防备。
猪价坐稳7元并有所突破 养殖户卖猪行为增多
目前利空北方猪价上涨的因素:猪价全面破7,养殖户出栏量增加;5月份为传统的牛猪出栏旺季;高温和雨水天气不利于北猪南调,猪肉消费市场将迎来传统消费淡季。虽然猪价没有下跌的可能,但是未来上涨幅度也不会过大。以前猪价持续上涨与基本面支撑和养殖户的压栏有很大的关系。因此现在要提价只能减少市场供应量,但是这个做法显然不现实。目前屠宰企业也在掣肘着猪价的上涨:养殖户增加出栏量,但是猪肉销售不畅的话必然引起屠宰企业的顺势压价。而且目前屠宰企业已经开始采取降低收购量来为自己解围。因此未来北方猪价上涨幅度不大,或仍以调整为主。如果上涨也难以维持持久的普遍性上涨,或多以涨跌互现为主。
外三元生猪均价为14.26元/公斤,较昨日上涨0.06元/公斤,较上周同期上涨0.42元/公斤。仔猪均价为28.35元/公斤,较上周同期上涨3.62%。白条猪肉均价18.95元/公斤,较上周同期上涨0.38元/公斤。今日猪料比价为4.38:1,较上周同期上涨0.13,猪粮比6.01,较上周同期上涨0.18。
全国地区生猪价格持续震荡上行,均价为14.26元/公斤。东北地区猪价维持震荡,局部出现微跌,主流价在13.7-13.9元/公斤;华北、华中、地区企稳,华东地区稳中微涨;广东猪价继续引领全国,局部地区已经涨至16元/公斤。全国最高价地区广东为15.40元/公斤,最低价地区黑龙江为13.70元/公斤。东北地区本周受外调困难较为明显,生猪价格持续震荡,预计调运恢复后,东北地区猪价全面突破14元/公斤问题不大。当前牛猪出栏依旧占据较大比例,缓解屠宰企业收购压力,且终端消费清淡,屠宰企业提价意愿不强,同时养殖户压栏惜售不减,两者博弈日渐激烈,持观望态度者越来越多。预计近期猪价涨幅不大,维持震荡小涨局面。
猪价坐稳7元并有所突破 养殖户卖猪行为增多
江西省养殖户反映今日本地出栏生猪外三每公斤14.6或14.8不等,缓扬中,江西上高。山西省稷山县养殖户报价生猪今日7元,今天卖64头,平均260斤。河南漯河养殖户反映今天卖猪,市场猪源少,7元零5分,有二头超重共扣100元。可见目前猪价已经稳坐7元,部分地区开始呈现温和突破的行情。但是现阶段养殖户的卖猪行为也开始增多,缓解了前期生猪市场供应紧缺的局面,加上猪肉消费清淡的制约,猪价将会继续呈现上涨乏力的态势。而且正如养殖户所说的,这几年生猪价格话语权一直操纵在几家大型屠宰加工企业手中,可谓家底丰厚。虽然今年的他们的处境比较尴尬,但是从他们的购猪策略上可以看出,屠宰企业在价格上并不会轻易松口。他们拥有雄厚的资金实力和库容,在猪价偏低时大量购进,即使市场上生猪供应量减少,由于库存充足也能支撑相当长的时间。
黑龙江省生猪价格连续六周攀升
据黑龙江省省物价监管局消息,黑龙江省生猪价格连续六周攀升。5月5日,生猪平均出场价格每500克6.80元,周环比上涨0.89%,与上月和年初相比,分别上涨15.84%、13.52%,与3月24日最低价5.47元相比上涨24.31%,同比上涨31.02%。
据黑龙江省物价监管局价格监测中心对黑龙江省肇东市、五常市、讷河市、呼兰区、五营区、望奎县等6个养猪大县(市、区)监测点监测数据显示生猪价格连续攀升。年初以来,我省生猪出场价格小幅下滑,到2月10日已连续11周下降,其后微幅震荡,至3月24日价格达到最低点,之后连续六周强势回升,近两周生猪价格高于全国平均价格。
物价专家分析,生猪价格上涨原因主要是由于当前生猪存栏量减少。由于近两年生猪价格持续走低,养殖户养殖利润减少,且出现连续亏损,部分散养户减少存栏或弃养。生猪外运量明显增加,外地客商增加了收购量,市场猪源减少。此外,养殖户市场预期增高,压栏心理加重,肉制品加工企业开工率提高,收购积极性增强,玉米价格高位运行促使饲养成本增加等因素也推升了生猪价格。从当前市场来看,由于生猪供应量持续减少,预计生猪价格将继续呈震荡上行的走势。
我们预计生猪价格在15年呈现平稳上涨
农产品(24.78, 0.28, 1.14%)行业第20周周报:猪价上涨有基本面支持一、本周重点行业观点
种植业
我们认为,大种植板块正在迈入黄金时代。原因主要是基于两点:(1)中国种植业在农业补贴提高、低息加杠杆、规模化经营三大因素作用下将迎来趋势性盈利反转;(2)农垦系统改革即将开花结果。2015年农垦改革将围绕农场企业化、垦区集团化与股权多元化等改革内容获得实质性的进展。
在此背景下,我们看好,上游农资环节模式变革和兼并重组,重点标的:农发种业(18.86, -0.43, -2.23%)、隆平高科(27.63, -1.31, -4.53%)、芭田股份(21.90, -0.87, -3.82%);中游环节看好市场化改革,重点标的:北大荒(18.76, -0.12, -0.64%);下游流通环节看好模式探索,重点标的:象屿股份(15.51, 0.13, 0.85%)(长江交运覆盖)。此外,在农业杠杆时代,农村金融服务模式亦值得重点关注,标的:大北农(17.99, -0.60, -3.23%)。
养殖业:
本周农业部公布生猪存栏统计信息,生猪去产能化的趋势依然在延续。其中能繁母猪存栏量下降至3971万头,环比下降1.7%,生猪存栏量环比小幅下降0.02%,目前存栏3.87亿头。
我们本周进行了河北地区的生猪草根调研。调查数据显示,河北地区能繁母猪实际整体淘汰量在30%以上,多以中小型养殖户为主,淘汰规模超出我们预期。
同时,和河南类似,河北地区冬季也出现流行性腹泻导致仔猪死亡率高。因此预计未来一两个月生猪猪源供应依然紧张,猪价在5、6月份有较大继续上涨可能。此外,虽然猪价行情猪价转暖,但由于资金压力,目前进行补栏的人数并不多,幅度低于以往。因此我们判断,母猪存栏将在低位维持较长时间,猪价依然存在较大的上行空间。
再次重申我们对于猪价将出现长期上涨趋势的判断。主要逻辑如下:按业内认为的能繁母猪存栏3300万头-3800万头规模计算,对应提供年商品猪出栏量5.1亿头-5.9亿头(psy15.5)。而2014年商品猪出栏量为7.35亿头,考虑消费结构转变因素未来几年国内年商品猪需求量也至少在6亿头以上。因此,假设能繁母猪淘汰率在25%-35%之间,未来12个月以后的生猪供给也将呈现供应短缺迹象。我们预计生猪价格在15年呈现平稳上涨(预计均价15元/公斤),16年表现为较快上涨态势(预计均价17元/公斤)。
陈春花:转型先读懂这四个变化
1、必须确立基于变化思考的习惯
市场非常现实,你以为看到了变化,其实是变化的结果。这意味着机会已经过去。而对于传统企业来讲,或许就意味着一场灾难,甚至是灭顶之灾。这已经不是危言耸听。
哈佛商业评论著文称这一波颠覆大潮与以往颠覆有着本质的不同,它称之为大爆炸式的颠覆。这种颠覆呈现出无可阻挡的开发、无可控制的成长、无章可循的战略特征。而“巨人倒下时身体还是热的”。因为当变化突如其来时,你已经没有迂回余地。它违背原来的竞争规律、产品无疾而终、消费者集体叛逃,替代你的却不是你看得见的对手,而是另外不同的产品服务策略。这种产品与服务,性能更好、价格却更低、定制服务更出色,这种完全不同的竞争策略,是因为计算机技术。
所以企业持续生存之道,是在自己随着一波浪潮崛起后,还要看到下一波浪潮的机会。我曾经在2006年著文《认识世界级企业》,着重表达了这种担忧。因为看到世界级企业无是不反复经过生死考验,并时刻保持着警惕不敢稍有松懈。我在文章中谈到对沃尔玛的关注:
“在非洲,每天早晨羚羊醒来。羚羊明白它必须跑得比狮子快,不然它会被狮子吃掉。每天早晨狮子醒来,狮子也明白它必须赛过跑得最慢的羚羊,不然它会活活饿死。不论你是狮子还是羚羊,都不重要……重要的是每天旭日东升,你就得开始奔跑!这句话就挂在沃尔玛前任CEO大卫.格拉斯(DavidGlass)办公桌对面的墙上,他也经常把这句话作为谈话的结束语。沃尔玛能够一直保持世界500强的领先者,很重要的一个因素就是能够一直保持和环境的匹配。”
现在我们可以近距离看到这个商业巨头的变化举动,2012年年底,沃尔玛在中国裁掉了20个采购办公室,全力发展一号店,迅速布局电商。2014年沃尔玛已经重回世界500强的榜首位置。我们可以想象一下,假设它不作出根本性的转变会怎么样?
这也给我们信心,企业经营之道是基于变化的思考,也必须基于变化的思考,而这也是组织转型的认知准备。如果你愿意变,一切皆有可能。
2、看懂四个变化
我们从前想不到的事情,今天全出现了;我们未来想不到的事情,也呈现在眼前了。那么如何看懂变化,这种基于变化的思考可以从哪几个角度看,是需要给组织成员明确的指引的。
变化一:没有永恒的成功经验,因为市场自己在变;
IBM全球CEO调查系列研究在过去的9年里,积累了深入的洞察和丰富的研究成果。我们可以看到中国企业经营发展的脉络,那些活下来、活得好、新涌现的企业做对了什么?
在2004年的时候,那些规模化的企业取得了成功。因为那时以收入增长为第一要务。许多在那个时期奋斗过的人知道,当时大家所要做的只有一件事情,就是不断寻求规模增长,因为机遇就在于你的规模。到了2006年,真正的机遇是来源于商业创新,那些以创新模式领导行业的企业持续获得了成功。到了2008年就需要有能力去做整合了。到2010年的时候,最重要的是什么?就是驾驭复杂性。
复杂就是不再是线性思维,而是模糊思维、多元思维。其最大的要求是什么?就是要接受不同的观点,同时还能明确地知道自己的观点是什么。如果接受别人的观点做出改变,却忘记了自己要做什么,这就说明你没有驾驭复杂性的能力。
到了2012年开始全面拥抱互联网。大家都知道,从2010年到2012年这个阶段,成长最厉害的公司是阿里巴巴,因为它全面拥抱互联网;第二个成长迅猛的公司是腾讯,因为它也全面拥抱互联网,这个时候,人们发现,增长也不再是线性增长,而是量级增长。
从2004年到2012年发展的历程告诉我们,如果学会基于变化的思考,就会发现,市场一直在变,所以机会一定是有的,我们不用担心说未来有没有机会,事实是每两年机会就会被调整一次,每次调整,你的机会就会来了,甚至到今天,调整的时间间隔已经缩减到一年,甚至更短,每天都在发生一些前所未有的变化。
变化二:互联互通的经济特点;
这个经济带来的最大改变是什么?就是员工对你的期望会变高,市场对你的期望也会变高,更重要的是,你所有的创新必须来源于这种广泛的联系,所以如果还是用原有的经验来做的话,就一定没有办法面对这个变化的世界了。显然,这次变化与以往不同。
我换个角度,用“共生”与“众享”来描述今天的经济特点,这个特点要去每个人都需要做出改变,不是你自己有多强大,而是你与谁联系在一起,去年我们还在为美的与小米的组合而惊奇的时候,今天万达与万科的联合更是让很多人“万万”想不到。有人认为两家公司的文化非常不同,合作后的价值仍待观望,但是我一看到这个信息就转发在自己的朋友圈,告诉大家这是我所乐见到的事情发生,因为互通互联才是关键。
几年前IBM提出“智慧地球”的三大特征之一就是“互联互通”时,我相信很多中国企业家并没有真正理解这个观点的价值,在今天,当看到苹果组合合作伙伴,改写手机行业的奇迹的时候,人们不仅仅惊呼“平台型企业”到来对行业的改变,更深深地认知到,联合发展的迫切性。也就有了我多次强调的那句话的认同:如果你说你与谁竞争,那你一定是错了;如果你说你与谁在一起,那你一定是对了。
变化三:影响组织绩效的外部力量是技术、员工和市场因素;
很多时候,人们并未关注到影响组织绩效的外部力量在发生着变化。大部分情况下,人们更关注行情、价格以及上下游供应商以及分销商的变化,关注政策、资源等要素的改变,甚至打架也会认为全球化是一个非常重要的因素,因为这些外部力量对企业的绩效会产生巨大的影响。的确如此,如果放在之前的情形中。
在今天,一个重大的发现是影响组织绩效的外部力量,其实跟行情没有太大的关系。甚至在很多行业与政策的关联度也没有那么大了,比如房地产;而在更大范围的领域里面,全球化似乎也不是一个关键影响因素,因为世界已经是平的。
那么在今天,什么因素是影响组织绩效的外部因素呢?第一是技术,第二是员工,第三是市场要素。互联网技术的影响之深、之大、之巨,不再需要我去累述,每个行业,每一个人都因其不得不做出改变,传统企业因为互联网技术,甚至集体陷入焦虑,那些行业领先者在互联网技术出现的时候,显得束手无策。市场要素本身一直是影响组织绩效的外部力量,这个也不需要我过多说明,我需要提醒的是“员工”。
我们习惯于把员工纳入为组织的内部力量,很少有企业把员工作为组织的外部影响因素去考虑。我之所以把员工作为组织外部因素,是因为今天的员工更应该理解为“人力资本”,而不是“人力资源”,“资本”本身的属性就是“趋利避害”,“市场化”与“社会化”,所以员工在今天拥有了从未有过的“独立性”以及“自由性”,组织的壁垒已经被打破,开放组织才可以让企业具有竞争力,而开放组织本身,也一定程度上给予员工释放自己价值的机会,这是一个非常重要的变化,需要好好去理解。
变化四:持续经济价值的主要来源将是人力资本、客户群、产品/服务创新。
企业获取持续的价值增长是极为重要的,我一直以来都认为,对于一个企业而言,规模大小并不是最重要的,最重要的是可持续性。因此,理解变化的第四个角度,就是对于持续性价值的判断,这需要从创造价值的来源去做判断。
企业的持续性取决于员工持续创造与创新的能力,如果企业拥有的成员能够不断地创造价值,不断引领变化,不断创新出新的商业模式,就如阿里巴巴的淘宝、支付宝、双十一,这些划时代的创造,一定是因为企业拥有无限创造能力,才会有这一切的出现,如果去看看阿里巴巴所诞生的亿万富翁、千万富翁的人数,你可以理解到这意味着什么。
这是一个互动与社会化的时代,因为互联网技术以及信息对称所带来的价值感知的改变,使得客户群会成为一个能够贡献持续价值的要素,不是拥有顾客或者客户,而是能够与客户建立关系,或者人们习惯所说的“社群”或者“粉丝”,建立起属于企业与客户的圈群文化以及黏性,持续性就会建立起来。这两天小米发布新品,很多人排大队等待;每一次苹果新手机的发布,都是一次营销的盛宴。
我一直很欣赏苹果和腾讯,一个是不断给你智能手机产品的惊喜,一个是不断给你人们交往便利性的惊喜,因为产品/服务创新,这两家企业走在持续领先的路上。很多时候,大家会问我,技术与市场改变巨大,如何才可让企业可持续,我总是很明确地回答,回归产品/服务,机会始终是你的。
这些变化已经是实实在在在发生,就看我们愿不愿意做出新的洞察和调整。能够理解形成洞察和洞察转化为行动企业就会成为优秀的企业。
如果量化一下,IBM的报告指出:能够形成洞察的企业,高出其他公司绩效的28%;能够将洞察转化为行动的企业,又高出其他公司绩效的26%。所以只要愿意去理解市场数据的变化,理解洞察的方向,将洞察转化为行动,我们就会有很多机会领先。
将洞察转化为行动需要组织转型去做配合,很多企业在组织转型上面临着许多挑战,虽然洞察变化已经是不容易的事情,但是更难的是如何将洞察转化为行动,即组织变革会更加有难度。所以我先请大家在组织转型的认知上做好准备,也就是拥有基于变化的思考习惯,然后再去展开组织转型的相关步骤,后面我会用一组文章,阐明如何进行组织转型。
用“科技+平台”为仔猪市场保驾护航
最近,不少地方仔猪价格不断上涨,有的地方还出现了仔猪供不应求的状况。在江苏省连云港市石梁河镇的苗猪市场,每天都有来自四面八方的苗猪贩子,载着一车车仔猪,争先恐后进入市场,赚的盆满钵满。仔猪价格的上涨和仔猪需求量的攀升,让仔猪市场的“春天”延长了,但仔细分析,我国的仔猪市场在发展上还存在一些问题。
第一,各地仔猪繁育场地分散,全国范围内仔猪集中繁育的大规模基地并不多,这就给目前仔猪交易市场的发展带来了很大的阻力。在这种情况下,养殖户对仔猪的培育、销售与购买者之间就会出现信息高度不对称的情况,具体表现在买家购进仔猪渠道不畅通,养殖户仔猪销售难觅出路。
第二,当下,大部分专业养殖户是跨地区购买仔猪,这个过程相当麻烦。前不久网上还纰漏了一位养殖户购买优质仔猪的经历,不仅需要花费半个月的时间,而且在购买过程中还要给当地经纪人许多中介费。可见,仔猪市场倘若想取得长远发展,这两个问题需要解决。
那么如何确保仔猪市场健康发展呢?笔者认为,相关部门应有所作为,不妨用“科技+平台”为仔猪市场保驾护航。
一方面地方政府应该加大对当地仔猪养殖户的专业技术指导,比如地方主管部门可以派科技工作者深入养殖户家中传授仔猪的科学培育方法,并积极组织养殖户联合起来建立大规模仔猪培育基地,这样当地的养殖户就可以不用跨地区购买仔猪了。
另一方面,为帮助养殖户买到优质仔猪,相关部门应积极搭建仔猪市场网上交易平台,供广大规模猪场和种猪企业免费发布仔猪供应信息,这样养殖户在家就能找到附近的卖家,从而简化仔猪购买流程。
各地区猪价存在差异性养殖户一定要具体问题具体分析
北方地区由于出栏量的增加猪价依然震荡调整。目前全国生猪供应趋紧局面难改,但是终端市场未有明显反弹。屠宰企业将会充分利用5月份震荡走势采取压价行为。虽然我们能够看到猪价走势基本面变化不会有大变化,但是部分地区有跌涨调整可能。
目前南方地区有那么几个突兀的高价区出现,多半还是因为屠宰收不到猪提价所致。未来要想出现全国范围内的行情冲高需要供应缺口的继续扩大以及猪肉价格主动的明显反弹。
目前各地区猪价存在差异性,养殖户一定要具体问题具体分析。不要看着别的地方涨价就死压自己的猪。另外超重猪和牛猪不一定就能够增加养殖利润,养殖户一定要理性压栏。
养猪“巨头”畜博会上“短兵相接”
5月19日,客商正在参观新型鸡舍。
中国每年引进的种猪价值超过1.5亿元人民币,成为国际种猪市场上的“好买家”——5月19日,在我市举行的第十三届(2015)中国畜牧业博览会暨2015中国国际畜牧业博览会上,几大养猪“巨头”在这里“短兵相接”。
美国、丹麦、荷兰、加拿大、英国、法国是目前世界上养殖业的几大“巨头”,此次畜博会上推介的主要产品也大多集中在种猪上。为了推介自己,吸引中国潜在买家的注意,各国都“蛮拼的”:英国“包下”了展场外主干道、悦来大道的灯杆广告;荷兰占据了国际馆进门主通道的有利地形,刮起“橙色旋风”;丹麦展团面积近900平方米,还设有免费的啤酒吧吸引人气……
有趣的是,这几个养猪“巨头”抢滩中国市场的方式,也不约而同地集中在“抱团”上。英国展团基本被该国种猪协会“占据”;由业主组建的美国国家种猪登记协会,表示将为客户提供养殖等方面的服务;荷兰展团的中荷猪业联盟,由在华经营与猪产业有关的荷兰企业自发成立,包括猪舍设备、屠宰等上下游产业链企业;丹麦除培育、销售种猪的丹育集团参展外,还带来“丹麦农场”概念,为中国企业提供从种猪到饲料、加工、粪污处理的完整产业链服务。
为何这么多国家热衷于“抢滩”中国?一位不愿具名的业内资深人士表示,一头种猪的售价可达1.5—1.8万元人民币,利润相当丰厚;而近几年我国年均引进的洋种猪数量在1万头左右。近期,受国际经济形势影响,全球种猪订单大幅下滑,育种水平相对较低、市场容量大的中国就成为国际市场上的“最佳买家”。
对此,这位业内人士表示,中国去年出栏生猪7.34亿头,其中有相当大的比例含有“外国血统”。中国在引进洋种猪的同时,也应高度重视自己的种猪培育工作,通过引进人才、发掘自己的畜禽遗传资源等方式,培育出更多耐粗饲、产仔率高、饲料转化率高的优良品种,开始由养猪大国向养猪强国迈进。
万头猪场科学养猪提质增效年盈利过百万元
5月13日,笔者来到位于第十三师红星四场五连养殖小区的旺农养猪专业合作社,猪场的工人正忙着用自动投料系统给猪备料,该猪场通过引进先进的设施和优良的品种,既节约了成本,又取得了可观的经济效益,走出了一条科学养猪,提质增效的路子。
2015年第十三师红星四场继续加强对专业化、标准化养殖的扶持力度,在资金和政策上给予倾斜,通过养殖业进小区,走规模化、集约化、产业化道路,打造出了以旺农养猪专业合作社万头猪场为代表的名优养殖企业。
旺农养猪专业合作社万头猪场,从2013年5月开始兴建,建设面积7千多平米,前期投资1000余万,拥有母猪室,保育室,仔猪室,育肥室,猪场目前有能繁母猪600头,后备母猪30头,种公猪6头,品种有杜洛克、约克和长白,全部采取人工受精,按1比100比例繁殖。该合作社通过引进意大利全进口自动投料系统、电地暖等先进设施,节约了人力物力,除此之外,该合作社还通过与正大饲料合作,获得了全程技术服务,单胎健仔数达到10头以上,取得了骄人的生产成绩。
据猪场场长朱艳平介绍:猪场现在主要销售15公斤左右的商品仔猪,月出栏达600头,到年底能出栏7千至8千头,平均一头仔猪盈利在150元左右,年盈利在100万元以上。
猪场效益节节攀高,该合作社决定在今年6月份新修4栋圈舍,主要以保育和育肥为主,从而实现自繁自育,以进一步扩大规模,提质增效。
替亡夫还41万外债养猪11年没吃几口肉
老公欠外债41万元,突然去世。作为妻子,可不可以不知情、装糊涂,“人死账烂”玩失踪?
葫芦岛农家女杜连君把外债扛肩头,带着儿子养猪11年,替夫还债22万。
养猪11年,她几乎很少尝到猪肉香,更没给自己买过新衣服,如今46岁的她头上生出白发,满脸褶皱。
“欠别人钱必须要还,即使我这辈子还不上,也告诉儿子要接力帮助还上,这是做人的根本。 ”
杜连君是这样说的也是这样做的。
“当时根本没想到再要回来1万多工资钱,杜连君送钱来给我弄一愣,感觉到有些出乎意料。 ”
债主们信任她的人品,11年还钱的光景里,没有一个人在她跟前耍横。
“当时欠的钱有一半是小工们工资,剩下的就是亲戚朋友的,人家也都拉家带口的,坑人家,我良心下不去。再说了,一个人欠别人的债不还,走到哪儿心里也不会安生。 ”
46岁的她头上生出白发,满脸褶皱。聊起11年的经历泪眼婆娑。
丈夫去世留下41万外债她一肩扛起
杜连君是葫芦岛兴城市旧门乡草白村人,和丈夫结婚后育有一个儿子。
丈夫很能干,除照顾农活儿外,1999年,还东挪西借20多万在本村承包了采石场,以此来减少部分村民外出打工无暇顾家的现状。
采石场起初前2年效益还不错,未拖欠过工人工资。尽管如此,也没有收回投资。正当其想大干一番事业时,对方却拒绝收购其产品,造成灰石积压严重,20余万原材料卖不出去,工人工资成了老大难。因心情郁闷,再加上着急上火,丈夫一病不起,后来企业停产,为此拖欠工资20多万元。
2004年下半年,丈夫被查出肝硬化和肝癌,大量吐血。尽管抢救治疗花了10多万元,还是撒手而去。
丈夫一走,留下了开采石场、治病欠下的41万元债务,连同一家老小的抚养义务。这些,一股脑都压在了杜连君纤弱肩膀上。
杜连君丈夫兄弟四个,公婆一直跟他们家过。丈夫去世后,公婆也没曾离开过她家。尽管去世前,丈夫告诉杜连君,一旦自己走了,就再找个人家,别苦了自己!可她拉着丈夫的手哭成了泪人儿,直摇头。杜连君甘愿伺候80多岁的公婆,拉扯着未成年的儿子。
从此,她把40多万元当作自己人生一道减法题的“被减数”,每天在心里盘算着,她盼望有一天这道题的结果能归于零。
压力袭来,杜连君整夜睡不着觉。夜深人静时,她暗自流泪,耳畔时常回响起乡邻的话:你还年轻,贤惠善良,走道儿算了。饥荒嘛,找死人要去。
杜连君说:“我动过那个心思,但只一闪念而已。儿子那时还小,公婆又年迈,谁来照顾?况且人走不能茶凉。当初丈夫和我借钱时,说好一定还的,就为了这句承诺,多大困难我也要挺过去。 ”
为一句承诺15岁儿辍学随母养猪还债
别看没有多少文化,可善良的杜连君认为,人必须要讲良心。“欠钱不还,让别人戳脊梁骨的事我不干,欠别人钱必须要还,即使我这辈子还不上,也告诉儿子要接力帮助还上,这是做人的根本。 ”杜连君是这么说的,也是这么做的。
一个女人,41万债务怎么还?靠种地,村里每人只有一亩来地,去了成本,不够生活费的。
想出外打工,一家老小谁来管?最后所有想法都行不通,杜连君选择了养猪。“养猪我在行,一开始没本钱,先从亲友那里赊来2头猪仔和饲料。从此用这2头老母猪开始繁育,养猪还债。在我精心饲养下,当年就还了两万多元。 ”
2005年,杜连君开始养猪,年仅15岁的儿子赵贺东不忍心看到母亲独自扛起家庭生活重担,于是决定辍学帮助妈妈共同养家。从此,这对母子一边打工、一边养猪,开始了还债生涯。
目前,除了帮助母亲在家养猪,赵贺东还给别人开车拉水、干零活儿挣钱。他一天累得腰酸腿疼,仍然坚强坚持着,因为他要帮助妈妈尽早还清外债。
杜连君指着院里一排猪舍说,“这些猪舍当初是政府出钱建的,养猪本钱是乡亲们借的。 ”
提起养猪的经过,杜连君眼里闪着泪花:“第一茬猪出栏的时候,没有一个人找我要钱,恰恰相反,有不少人反倒安慰我,别着急还钱,慢慢滚雪球,你会好起来的。 ”
昨日46岁的杜连君正在喂猪,丈夫开采石场时欠工人的22万元工资已经还清,还债11年,她的头上已生出白发,满脸褶皱。
养猪场老板私自将死猪扔进水塘 已进行深埋处理
视频:橙色娘子军:死猪扔进水塘 污染大 村民烦
今日,荆州区纪南镇纪南村的村民跟记者打来电话,说就在他们家附近,一个养猪场的老板竟然私自将死猪扔在水塘里,污染很大,情况是否属实,记者马上赶了过去。
一走近养猪场,记者就闻到了一股臭味。仔细一看,发现旁边的池塘里确实漂浮着几头死猪,而且经过水的浸泡,死猪身体已经发肿。附近村民告诉记者,天气热了,死猪在水塘里会滋生细菌,并且村里的灌溉渠就在旁边,村民担心,养猪场排出的粪便会污染水源。
正当记者拍摄时,养猪场的老板出现了。他承认,死猪确实是他厂里的,都是一些小猪崽。
老板说,这个养猪场已经有了五年时间了,之前也会有一些死猪,一般他们都是挖坑深埋的,这次因为塘里养了鲢鱼,将小猪扔下去,也是为了养鱼。
可是,不管什么原因,这死猪随便乱扔明显污染环境,随后记者联系了荆州区畜牧局,畜牧局的工作人员告诉记者,根据《湖北省畜牧条例》的相关规定,畜禽死亡随意处置由村里直接管理和处罚。随后,记者将这个情况反映给了当地的村委会。
村主任说,这个养猪场他们也知道。之前村民就反映过,村里也和养猪场的老板进行过沟通。双方达成共识,必须建一个沼气池。
荆州区纪南镇纪南村副主任周金海说,他们现在正在申办沼气池,要等上面批复。
随后,记者和村里的副主任一起来到了养猪场,要求养猪场老板立即把死猪捞起来深埋。
在记者和村干部的督促下,养猪场老板将池塘里的死猪捞起来进行了深埋。
唐人神收购龙华农牧90%股权
唐人神今日发布公告称,唐人神拟以发行股份及支付现金的方式向龙秋华、龙伟华购买其合计持有的湖南龙华农牧发展有限公司(简称“龙华农牧”)90%股权。这意味着唐人神强化了生猪养殖基地建设,直接控制养殖终端,更能确保肉品安全。
公告称,龙华农牧100%股权的预估值为32,528.22万元,合计持有的90%股权对应的权益价值为29,275.40万元。经交易各方友好协商,拟确定龙华农牧90%股权交易对价最高不超过29,250.00万元。其中唐人神以发行股份方式支付交易对价中的24,862.50万元,股份发行价格为11.07元/股;以现金方式支付交易对价中的4,387.50万元。
根据《上市公司重大资产重组管理办法》的规定,本次交易不构成重大资产重组,但由于本次交易涉及发行股份购买资产,故需提交中国证监会并购重组审核委员会审核。
位于茶陵县下东乡的湖南龙华农牧发展有限公司,始创于2005年,是湖南省生猪养殖领域的骨干企业,目前已具备商品猪12万头的生产能力。其“自育自繁自养规模集约化”的经营模式,能对生产各环节进行全过程控制,有利于提高食品安全与产品质量。
长春“二师兄”身价涨得有点快!


“二师兄”最近表现有点活跃,去年市场低迷的猪肉价格近期却意外走上了上升的轨道,而且大有一路“小跑”的趋势。
根据5月18日长春市价格监督检查局监测数据显示,与3月份相比,长春市猪后臀价格平均每斤涨了1.2元,达到11.1元/斤。是什么原因让肉价“回暖”?肉价到底还能涨多少?是否会重复此前的“猪坚强”?CPI要想走出“1”时代,为何要看猪肉价格走势?
3月过后猪肉价悄然上扬
昨日,记者走访了长春市部分农贸市场,发现与3月份相比,猪肉价格最近涨得有点快,猪后臀市场平均零售价格已涨到11元/斤。在繁荣路农贸市场,猪后臀的价格在12元/斤,近埠街农贸市场的猪肉价格在11.5元/斤。
“这段时间肉价一直在涨。”一位猪肉零售摊贩告诉记者,长春市猪肉价格是3月份涨起来的,涨到现在,每斤能涨1元多。“感觉这肉价还得涨。”她凭着经验判断。
记者从长春市价格监督检查局监测数据看到,年初时,长春市猪肉平均价还在10.6元/斤,到2月中旬跌到9.7元/斤左右,进入3月初,价格开始上涨。从3月2日的9.9元/斤涨到5月18日的11.1元/斤,价格上涨12.1%。
猪肉价格上涨在全国已经形成趋势。根据国家统计局数据,今年3月份以前,猪肉价格同比涨幅已连续14个月为负,今年3月才止跌,同比涨2%。4月,猪肉价格更是同比大涨了8.3%。5月,猪肉价格继续延续此前大涨走势。
据农业部监测数据显示,5月第一周全国规模以上生猪定点屠宰企业白条肉出厂均价回升至9.2元/斤,连涨6周。
我省猪粮比进入绿色区域
猪肉零售价格上涨意味着生猪收购价也在回升。
去年猪肉价格一直低迷,让农安县生猪养殖户万长军赔了70多万元。他对生猪养殖行业越来越灰心,“养猪不如去打工赚钱。”他曾负气地表示。
今年熬到3月份时,他感觉一波上涨行情,生猪收购价格开始一点一点回暖。“上个月生猪收购价最高涨到7元/斤了,但是这几天又回落到6.6~6.7元/斤了。”万长军说。
“现在养猪成本也高,生猪收购价不达到7.2元/斤我都不赚钱。”虽然目前生猪收购价还没有达到万长军的预期,但是对今年下半年猪肉行情,他还是抱些希望。“我现在不太敢预测,猪肉哪有周期了,不过养殖户也在观望,现在家里有200多头体重达300多斤的育肥猪没卖,我想再等等。毕竟赔了一年多了。”
昨日,记者从吉林省物价局对我省主要县市监测数据看到,3月份,全省生猪收购均价5.74元/斤,月度环比下降1.71%。仔猪销售均价12.74元/斤、猪后臀市场零售均价10.74元/斤,月度环比均上升,升幅分别为34.25%、0.19%。与去年同期相比,生猪、猪后臀价格分别上升7.49%、8.05%。仔猪价格下降17.27%。猪粮比价在5.10:1至5.31:1之间波动,处于价格中度下跌的黄色预警区域。生猪养殖行业处于中度亏损状态,且亏损程度逐步加深。
5月13日的监测数据显示,我省生猪收购价涨到6.88元/斤,仔猪销售均价为18.5元/斤,周环比均上涨。我省猪粮比也升至6.25:1,处于绿色区域,生猪养殖行业保持盈利状态。
■预测
下半年猪肉价还涨
虽然目前肉价走出了涨势,但是在万长军心里还没有底。
卓创分析师刘丽分析认为,推动今年猪肉行情的主要原因是供应量趋紧。“首先二季度时我国生猪存栏量进入阶段性供应低位,对猪价形成提振;其次猪价开始上涨后,亏损已久的养殖户压栏惜售,且此情绪蔓延至今,导致市场猪源更加紧张,屠宰企业收购难度大,被迫上调收购价。”
刘丽认为,二季度末及三季度,生猪供应紧张情况难以出现实质性缓解,在此期间需求低迷的利空影响较弱,猪价延续震荡上行的可能性大。
国内知名生猪分析师郭会勇认为,下半年肉价还会有上涨空间,南方猪肉价格会涨到17元/斤左右,“再高的可能性很小。”
国务院发展研究中心宏观经济部研究员张立群认为,由于过去两年生猪价格持续走低,养殖户养殖利润连续亏损近20个月,由此出现部分中小散养殖户减少存栏或弃养现象,目前全国猪肉供应呈现整体偏紧的格局,而且随着夏季到来,母猪的产仔率、个体肉猪的重量都有下降的趋势,2015年全年猪肉价格都将以回暖为主。这意味着,猪肉价格后续仍有较大上扬的可能,后期可能推动CPI持续上扬。
猪肉价推着CPI上涨?
自去年猪肉价格低迷以来,全国居民消费者价格指数(CPI)走势也是下降的,已连续8个月在“1时代”甚至“1时代”以下徘徊。有业内人士分析认为,CPI再度高出“1”时代,要看猪肉价格走势。
从数据显示,今年3月份以前,猪肉价格同比涨幅已经连续14个月为负,今年3月才止跌,同比上涨2%。4月,猪肉价格同比大涨了8.3%,涨幅较3月扩大6.3个百分点,影响居民消费价格总水平上涨约0.22个百分点。生猪价格的确从3月中下旬开始震荡上行。数据显示,4月猪价继续上涨,截至目前,全国22省市生猪平均价已超过6.5元/斤,一个多月累计涨幅约12%,多地甚至冲高突破7元/斤大关。
原来,在CPI衡量的一揽子商品价格体系中,猪肉价格对CPI的影响最为显著。
数据显示,2012年至2014年,猪肉占CPI的权重分别为3.27%、3.20%和3.15%。整体看,2009年以来猪肉平均价与CPI同比增速之间的相关系数达到0.91。
刘丽认为,从整体来看,二、三季度猪肉价会推动CPI指数上扬。

周星驰饰演的猪肉佬形象风度翩翩,但现实中香港年轻人不愿入行。 图片为剧照
月入两万港元,但香港猪肉档仍招不到“猪肉佬”。香港猪肉业界关注人手短缺,担忧从业员青黄不接,估计现时缺少500名鲜肉刀手。前日,香港鲜肉业界约见港府相关负责人,希望推出政府资助的鲜肉培训课程,并希望外界视从业员为“肉类分割技术员”,勿当他们“猪肉佬”。
香港猪肉界缺500刀手
香港猪肉业界关注人手短缺,担忧从业员青黄不接,估计现在香港欠500名俗称“猪肉佬”的鲜肉刀手。为此,10多名业界代表前日在香港立法会议员陪同下,到港府总部会见港劳工及福利局局长张建宗,要求增拨资源,开办鲜肉刀手培训课程。
全港鲜肉零售业联席会议召集人许伟坚会后表示,会上达到一定成果,张建宗承诺雇员再培训局将增拨资源支持业界再培训,最快有望今年可开办课程。许伟坚表示,希望外界视从业员为“肉类分割技术员”,勿当他们“猪肉佬”。他透露,现时刀手日薪900至1000元(港元,下同),每日工作9小时,工作稳定,月入可在2万元以上。他希望将来将鲜肉刀手改为月薪制,以吸引新血入行。
香港筲箕湾猪肉档的档主陈先生,入行已有40多年。他坦陈“猪肉佬”收入不错,新入行月入可达12000至13000港元,熟手技工月入更有20000至30000元,但他慨叹“朝五晚八,还要无假放,年轻人不肯入行”。
对港府计划开办刀手课程,他直言效用不大,即使学成技术,但如果年轻人不愿入行,培训也没用。他透露,愿意做刀手的年轻人,绝大部分都是内地新移民。香港生猪工会理事长陈展明表示,行内大部分刀手年过六旬,即将退休,鲜肉档和屠场正面临人手荒。他指业界希望开办全日制就业挂钩的肉类切割技术员课程,学费全免,每日可获逾150元津贴,吸纳60至70岁人士和轻度残障者等入行。
刘舜才:关于养不好猪的关键问题分析
我简要说说我的思考:
1、老板是谁:
老板的素质和思路决定了一个行业的水平。大多数投资养猪的人都不是把养猪作为事业来干的,而是按做生意的想法来干事业。
大猪场老板:
①大猪场中的大部分老板是因为他有关系可以拿到政府的项目才做养猪的;
②另外一些老板,是做别的行业赚了钱,听说养猪好赚才投资进来的;
③还有一部分是官员洗钱的。这三类老板,都难以赚钱,第一种老板等着套政府的补贴;第二种老板钱亏完再说;第3种老板亏一点没关系。
中小猪场老板:
多数中小猪场的老板,是被自我膨胀+政府鼓励+饲料厂(经销商)忽悠和赊账才稀里糊涂做到这个规模的。当他们做上去之后才发现养猪赚不到钱,一年盼一年,盼个好价钱,可事与愿违,猪价越来越低,最
后无以为继。
为什么那么多没有专业也不懂养猪的老板们敢前赴后继地投入到这个行业里来呢?梅双利先生说得好:“饲养观念出了问题:没有养过猪的都觉得养猪很低端,非常容易,我只是嫌弃他脏,累,如果我认真去搞就可以搞好。”
2、规模和技术
养殖业和种植业一样,没有一定规模就谈不上技术、经营和管理,好在目前正在向规模化的方向迈进。
3、政府捣乱
按照经济学原则任何一个产业都应该让市场自己来调节,而我们的政府插手养殖业的结果是大量的财政资金给了那些有关系而不一定懂养猪的人,补贴也刺激了产业的超速发展和过剩,最后导致大家亏损,损害的是那些很认真从事养猪的人和消费者。
4、从业人员
①大学教育脱节——没有足够的专业技术人员支撑本产业;
②产业地位低下-很少有人愿意真心去做,多数是没有选择了才去做养猪的;
③效率与效益低下导致人才流失;
④缺少人才又导致技术-管理-执行都不到位,养殖成本进一步恶化
5、要素分析,以上因素中:
①政府不管多混蛋我们目前是管不了的,忽略这个因素;
②老板是可以教育和改造的;
③从业人员可以和产业一起改变;
④中国目前“有钱”,技术也没什么大不了的。规模和技术不是关键问题。
所以,我觉得,改变老板的观念,才是目前可以牵一发而动全身的关键要素。
6、宏观上讲,我们的出路在哪里?
① 猪场规模化;
②大公司(掌控关键技术、经营、管理)+小猪场(养殖);
③进口。
我们的猪为什么养不好?
武正发先生:
时间不够,列个提纲
①劣质原料困扰,优质原料太少
②造肉、繁殖、防疫方法不对
③国家营养标准out
④养殖环境恶劣
⑤真把猪当“猪”来养了
孟凡杰:
猪的心情不好,对猪来说环境差,密度大
梅双利:
我觉得还是饲养观念的问题:所有没有养过猪的都觉得养猪很低端,非常容易,我只是嫌弃他脏,累,如果我认真去搞就可以搞好。我认识的养了十年以上的养殖户不说手上有很多钱,但手上还是有资金的,行情低迷时不至于赊欠饲料
讨论:
杨育才:
瓶颈往往在瓶子的顶端,这是行业上半场营销培训很让老板们受伤的原因,讨论的矛头最后往往对准了管理层甚至直指老板眉心。
刘舜才:
老板是不同意这个说法还是不愿意改变呢?还是想要改变不知道怎么变?
老板需要被启迪而不是被羞辱;老板需要找到关键问题,而不是稀里哗啦罗列一大堆问题;老板需要可以实操的策略,在方法上越简单越好,而不是引用海量术语和装逼,让人越搞越糊涂,甚至的越搞越糟
——不请顾问是死,请了顾问死得更快!!
老板需要找到他可以信任的人,怎么信任呢?会说人话,把复杂问题看透后能够简单表述和形成简单的策略与方法。
另外,老板做得顺的时候是听不进去所谓的忠言逆耳的;等他真的顶不住了才开始想借外脑,这时候遇到几个忽悠高手,他可能被骗几次之后也就没有信心再信任谁了。
杨育才:
健康的企业看起来都差不多,有病的企业却病得各有千秋,让市场做主就是让该死的企业去死,让健康的企业注意身体,新陈代谢挺好。「这样是不是听起来舒服点」
德国批准新的抗菌素耐药性战略 呼吁人医和兽医国际合作
“我们已经取得了重要的进展,现在不仅要在国家的层次上进行努力,而且还有在国际的层次上进行努力。

德国联邦卫生部长赫尔曼·格罗厄(Hermann Gr?he)
PIG SITE官网5月19日报道称,德国联邦内阁日前已批准了新的“德国抗菌素耐药性战略”(DART 2020)。
据了解,DART是联邦健康部(BMG)、联邦食品与农业部(BmEL)和联邦教育与研究部(BMBF)的一个共同战略。DART 2020的目标之一就是在国家和国际水平上加强“同一个健康”方式,相关部委之间通过跨部门工作组来合作减少人医和兽医领域的抗生素用量,并且对人畜共患病方面的研究协议进行更新。这些联邦部委将支持技术上相关的国际组织在全世界范围内与抗生素耐药性进行斗争。
德国联邦卫生部长赫尔曼·格罗厄(Hermann Gr?he)表示说,“当抗生素无效的时候,我们就面临着不得不回到前青霉素时代治疗方式的威胁,而这会造成剧烈的后果。”
“抗生素耐药性在全球范围的传播需要被制止。”Hermann说,“我们已经取得了重要的进展,现在不仅要在国家的层次上进行努力,而且还有在国际的层次上进行努力。
“有必要针对人医和畜牧业的抗生素使用制订清晰的规则,并且研发新的抗生素、替代疗法,以及快速诊断试验。” Hermann说,“没有任何国家能够独自阻止抗生素耐药性的泛滥,因此我们必须共同把这个问题在国际社会提出。
“下周在WHO(世卫组织)我们将提出一个共同路线图。而在6月的G7峰会上,我们已经把这个主题提上了日程。” Hermann说,“通过新的德国抗菌素耐药性战略,我们正在各个层次上推动与抗生素耐药性的斗争。”
德国联邦内阁日前已批准了新的“德国抗菌素耐药性战略”(DART 2020)
德国联邦农业部长Christian Schmidt强调,抗菌素耐药性的封锁对于人类和动物的健康都是至关重要的。 “我们已经创造了药物持续减量的条件。”
德国联邦研究部长Johanna Wanka说,“DART 2020的目的是防止抗生素耐药性的产生和扩散。它并行地在人医和兽医领域采取了各种措施。此外,这项战略应有助于加强新抗生素、替代疗法,以及快速诊断试验的研究与开发。”
“动物和人类常常会感染相同的病原,并且用相同的抗生素来治疗。因此,只有通过跨部门的方式,才能有效封锁抗生素耐药性的产生与传播。” Johanna说。
因此,DART 2020与“同一个健康”的实施是一致的。
免责声明:
1、凡注明为其它媒体来源的信息,均为转载自其它媒体,转载并不代表本网赞同其观点,也不代表本网对其真实性负责。
2、您若对该内容有疑问,请即与本网联系,本网将迅速给您回应并做处理。
3、本网站将尽力保证服务的及时性、客观性,但不保证服务一定能满足用户的要求,也不保证服务不会受中断。本网站所提供的所有信息和数据服务仅限于用户参考,不对用户的商业运作做任何具体性指导。用户因参考本网站提供的信息所带来的一切风险及法律后果由用户自行承担。
1、凡注明为其它媒体来源的信息,均为转载自其它媒体,转载并不代表本网赞同其观点,也不代表本网对其真实性负责。
2、您若对该内容有疑问,请即与本网联系,本网将迅速给您回应并做处理。
3、本网站将尽力保证服务的及时性、客观性,但不保证服务一定能满足用户的要求,也不保证服务不会受中断。本网站所提供的所有信息和数据服务仅限于用户参考,不对用户的商业运作做任何具体性指导。用户因参考本网站提供的信息所带来的一切风险及法律后果由用户自行承担。










































































































